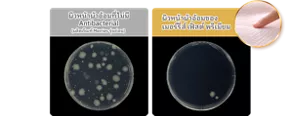
ผิวหน้าผ้าอ้อมที่ไม่มี Antibacterial (ผลิตภัณฑ์ Merries รุ่นก่อน)   / ผิวหน้าผ้าอ้อมของ เมอร์รี่ส์ เฟิสต์ พรีเมียม
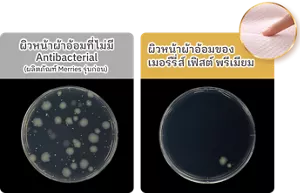
ผิวหน้าผ้าอ้อมที่ไม่มี Antibacterial (ผลิตภัณฑ์ Merries รุ่นก่อน)   / ผิวหน้าผ้าอ้อมของ เมอร์รี่ส์ เฟิสต์ พรีเมียม

เพราะเมอร์รี่ส์ปรารถนาให้ลูกน้อยสัมผัสถึงความสบายตัว
เมอร์รี่ส์จึงคัดสรรวัสดุคุณภาพดี
และให้ความสำคัญกับผิวหน้าผ้าอ้อมที่สัมผัสผิวลูก

The only one in Japan
*Antibacterial บนผิวหน้าผ้าอ้อม*

ภาพผลการทดสอบโดย JIS (L 1902:2015)
* ในผ้าอ้อมเด็กสำเร็จรูปแบบใช้แล้วทิ้ง จากการวิจัยบริษัทคาโอ โดยใช้ฐานข้อมูล Mintel และอื่น ๆ



นุ่มขึ้น 2 เท่าดุจแคชเมียร์* สัมผัสนุ่มละมุน อ่อนโยนต่อผิวเด็กด้วยวัสดุคุณภาพสูง *ผิวหน้าผ้าอ้อมเทียบกับผลิตภัณฑ์เมอร์รี่ส์เจแปนแพนท์



วัสดุระบายอากาศได้ 100%*ลดความอับชื้นและระบายอากาศได้ดีทั่วทั้งแผ่น
ผิวลูกน้อยรู้สึกแห้งสบาย*ยกเว้นบริเวณเทปพันทิ้ง



Soft Poo Absorption
Fluffy Air-in Cushion ด้วยพื้นผิวผ้าอ้อมที่เป็นเอกลักษณ์ รูปทรงนูน
เป็นลอนพิเศษ ช่วยดักและป้องกันการกระจายตัวของอุจจาระเหลว
ไม่ให้ติดกับผิวของลูก



ผสานสารสกัด Argan Oil**สารสกัด Argan Oil บริสุทธิ์จากธรรมชาติ
บนผิวหน้าผ้าอ้อมที่สัมผัสกับผิว



ภาพประกอบ



*การออกแบบและสีของผ้าอ้อมอาจแตกต่างจากผลิตภัณฑ์จริง
1 ดีไซน์ ต่อ 1 แพ็ค

สำหรับเด็กแรกเกิด - 5 กก.

ไซส์ S
(4-8 กก.)




เมื่อลูกน้อยที่เริ่มขยับตัวเก่งขึ้น พลิกตัว และเริ่มคลาน

เมื่อการเปลี่ยนผ้าอ้อมทำได้ยากขึ้น

เมื่อลูกน้อยดูไม่สบายตัวในขณะที่ติดเทปได้ถูกต้อง

เมื่อต้องแกะเมจิกเทปและติดใหม่เป็นประจำเนื่องจากลูกน้อยเริ่มขยับตัวเก่งขึ้น

ขอบเอวนุ่มแนบกระชับสรีระป้องกันการรั่วซึมทำให้ผิวลูกน้อยแห้งสบาย
แม้เคลื่อนไหวมาก

ขอบเอวขยายได้กว้างมากขึ้น 2.5 เท่า* สัมผัสนุ่ม ไม่รัดขอบเอว
สวมใส่ง่าย กระชับรอบเอว และขอบขา*เทียบกับก่อนยืดจากการวิจัยบริษัทคาโอ
ภาพประกอบ
ภาพประกอบ
ยืดขยายได้ เก็บได้มิดชิดไม่เลอะเทอะ เพื่อความสะดวกและสุขอนามัยที่ดี

*ส่วนที่ยืดขยายได้ถึง 10 ซม. *อาจขาดได้หากยืดออกมากกว่า 10 ซม.

*การออกแบบและสีของผ้าอ้อมอาจแตกต่างจากผลิตภัณฑ์จริง
2 ดีไซน์ ต่อ 1 แพ็ค

ไซส์ M
(6-11 กก.)

ไซส์ L
(9-14 กก.)

ไซส์ XL
(12-22 กก.)